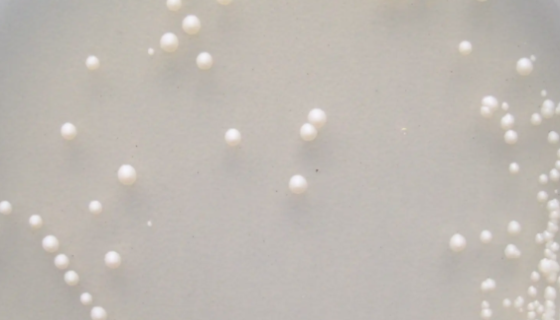
酿酒酵母——用于制作面包和馒头等食品及酿酒

变形杆菌的迁徙生长及菌株特点与防治方法!
变形杆菌属(Proteus)也是属于肠杆菌科。变形杆菌食物中...

可可毛色二孢菌——药用植物内生菌
可可毛色二孢菌是Lasiodiplodia属的微生物,原产地...

人脂肪干细胞的处理方法与培养步骤及注意事项!
脂肪间充质干细胞是从脂肪组织中分离得到的一种具有多向分化潜能...

ATCC 43137 多杀性巴氏杆菌 百欧博伟生物
多杀性巴氏杆菌是一种微生物,又名多杀性巴士杆菌。多杀性巴氏杆...

异常球菌属的菌株简介与保藏条件及注意事项!
异常球菌属细胞球状,直径0.5~3.5 μm,成对或四联,比...

小鼠软骨肉瘤细胞收到后的处理方法与培养步骤!
小鼠软骨肉瘤细胞收到后的处理方法与培养步骤及注意事项!

LKT-1高温厌氧杆菌属 百欧博伟生物 ATCC 33488
高温厌氧杆菌属,单生或成串联成短链生长,革兰氏染色阳性,产圆...
酿酒酵母——用于制作面包和馒头等食品及酿酒
酿酒酵母(Saccharomyces cerevisiae)...

绿色木霉的使用方法与注意事项及打管说明!
绿色木霉是木霉菌的一种,在自然界分布广泛,常腐生于木材、种子...